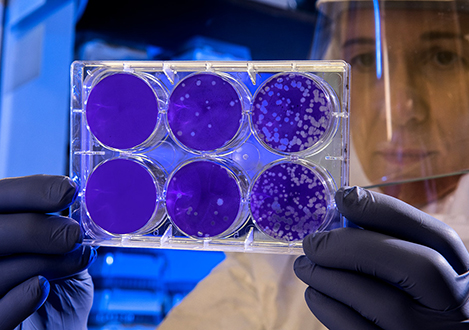

Láminas Acrílicas
Contamos con medidas estándar y también podemos producir planchas con medidas específicas.
| 1.25 x 1.85 m |
|---|
| espesores |
| 1.5mm |
| 2mm |
| 3/32" (2.4mm) |
| 3mm |
| 4mm |
| 3/16" (4.8mm) |
| 1/4" (6.4mm) |
| 8mm |
| 3/8" (9.5mm) |
| 1/2" (12mm) |
| 1.50 x 2.50 m |
|---|
| espesores |
| -- |
| -- |
| 3/32" (2.4mm) |
| 3mm |
| 4mm |
| 3/16" (4.8mm) |
| 1/4" (6.4mm) |
| 8mm |
| 3/8" (9.5mm) |
| 1/2" (12mm) |
| 1.25 x 2.45 m |
|---|
| espesores |
| -- |
| 2mm |
| 3/32" (2.4mm) |
| 3mm |
| 4mm |
| 3/16" (4.8mm) |
| 1/4" (6.4mm) |
| 8mm |
| 3/8" (9.5mm) |
| 1/2" (12mm) |
(+51) 9088 47874